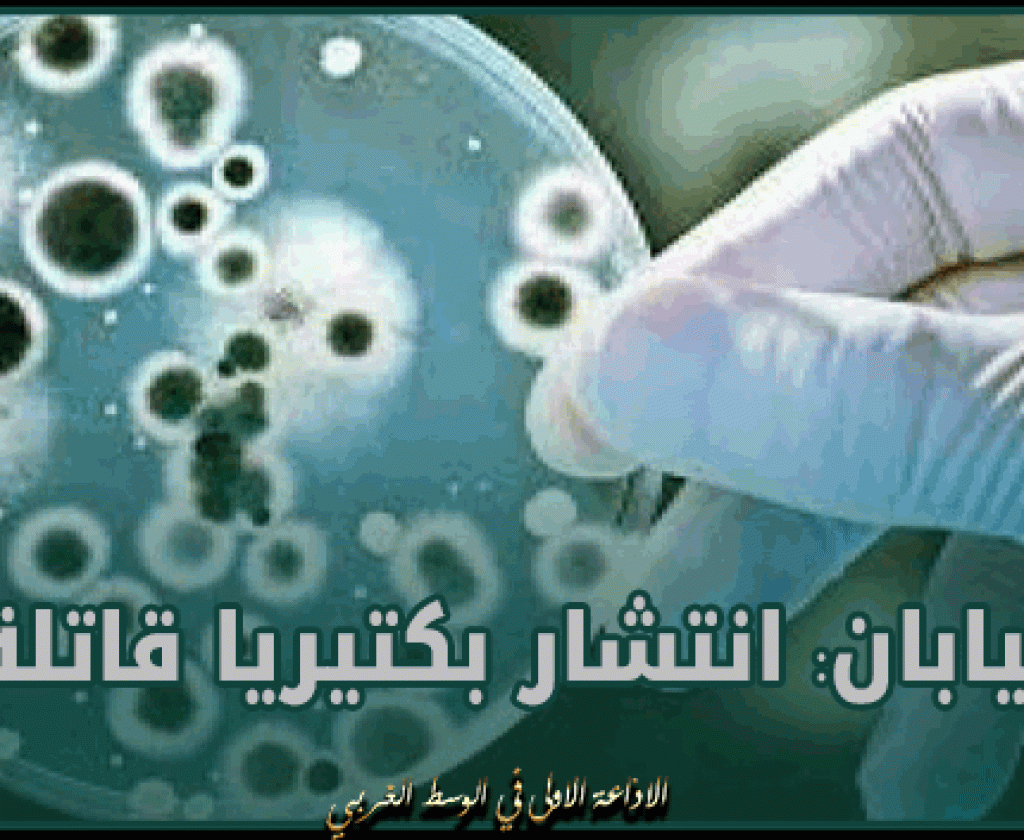
اليابان: انتشار بكتيريا قاتلة

عين دراهم: إخلاء مساكن متضررة إثر التقلبات الجوية الأخيرة
عين دراهم: إخلاء مساكن متضررة إثر التقلبات الجوية الأخيرة
اليابان: انتشار بكتيريا قاتلة
ويتزايد القلق من أن الشكل الأقسى والمميت من بكتيريا "المكورات العقدية" أو "Streptococcal" سيستمر في الانتشار، بعد رصد سلالات شديدة الخطورة والعدوى في اليابان.
ومن المتوقع أن يتجاوز عدد الإصابات في عام 2024 الأرقام القياسية المسجلة خلال العام الماضي.
وقال المعهد الوطني للأمراض المعدية في اليابان: "لا يزال هناك العديد من العوامل غير المعروفة فيما يتعلق بآليات انتشار هذه البكتيريا، ونحن لسنا في المرحلة التي يمكننا من خلالها تفسيرها".
وسجلت الأرقام الصادرة عن المعهد الوطني للحساسية والأمراض المعدية في اليابان، 941 إصابة تم الإبلاغ عنها في العام الماضي.
لكن في الشهرين الأولين فقط من عام 2024، تم بالفعل تسجيل 378 حالة إصابة، مع تحديد حالات العدوى في جميع محافظات اليابان البالغ عددها 47، باستثناء اثنتين.
وفي حين أن كبار السن يعتبرون أكثر عرضة للخطر، فإن سلالة المجموعة "أ" من بكتيريا المكورات العقدية تؤدي إلى المزيد من الوفيات بين المرضى الذين تقل أعمارهم عن 50 عاما، وفقا للمعهد.
وذكرت صحيفة "أساهي شيمبون" المحلية، أن من بين 65 شخصا تحت سن 50 عاما تم تشخيص إصابتهم بالبكتيريا بين جويلية وديسمبر 2023، توفي حوالي الثلث، أو 21 شخصا.
(سكاي نيوز)
عين دراهم: إخلاء مساكن متضررة إثر التقلبات الجوية الأخيرة
بداية من غدا الأربعاء: أشغال صيانة بجزء من الطريق السيارة أ1
دوي في الدوحة.. صافرات الإنذار بالبحرين والإمارات تتعامل مع صـ..ـوا ر يـ ـخ
